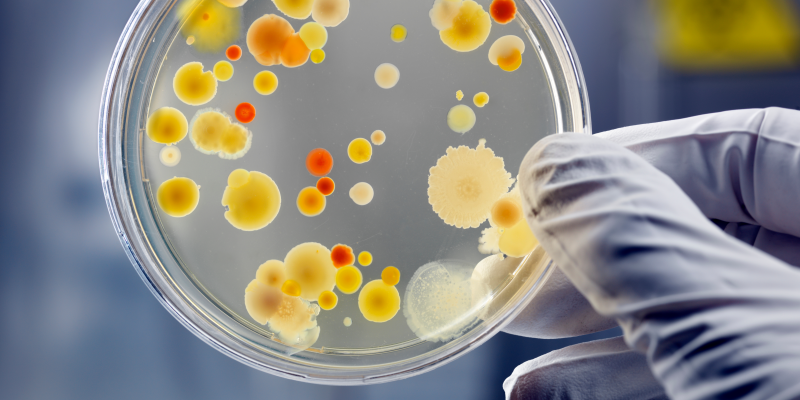
The fight against AMR

by Stephan Lust | Jan 18, 2023 | Health day
Amsterdam, 18 January 2023 – January is Cervical Cancer Awareness month, an important time to educate ourselves about this disease and take steps to prevent it. As procurement agent for Defeat NCD (DNCD), IDA Foundation is committed to increase access to...

by Stephan Lust | Dec 12, 2022 | Health day
Amsterdam, 12 December 2022 – On Universal Health Coverage Day we raise awareness of the importance to leave no one behind. At IDA Foundation, it is our mission to bridge the gap in access to medicines and we have adopted Universal Health Coverage (UHC) as one of...

by Stephan Lust | Nov 18, 2022 | Health day
Amsterdam, 18 November 2022 – Today is the kick-off of the annual World Antimicrobial Awareness Week (WAAW). This week aims to create awareness around the accelerated threat of antimicrobial resistance (AMR). AMR occurs when bacteria, viruses, fungi and parasites...

by Stephan Lust | Aug 17, 2022 | Health day
Amsterdam, 17 August 2023 – Coming Saturday on the 19th of August we honour World Humanitarian Day! On this day awareness is raised for those people helping others around the globe. For example by supporting refugees who are fleeing from political conflict or by...

by Stephan Lust | Jul 26, 2022 | Health day
Amsterdam, 28 July 2022 – Today is World Hepatitis Day! On this day we raise awareness about the impact and long-term effects of viral hepatitis. Besides causing acute inflammation and illness, chronic hepatitis infection increases the risk of developing liver...

by Stephan Lust | Jun 14, 2022 | Health day
Amsterdam, 14 June 2022 – On World Blood Donor Day we raise awareness of the need for safe blood and blood products. Worldwide, blood donors are very much needed and thus we thank voluntary, unpaid blood donors for their live-saving gifts of blood. In addition we...